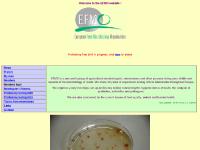
Topics from recent years, Links

Efmny.org
Efmny is ranked 816,814 in the United States. 'Epilepsy Foundation of Metropolitan New York.'
816,814Rank in United States
--Worldwide Rank
| Monthly pages viewed | < 300 | |
| Monthly visits | < 300 | |
| Value per visitor | $0.88 | |
| Estimated worth | $669.18 | |
| External links | 8 | |
| Number of pages | -- |
Last Updated: 04/15/2018 . Estimated data, read disclaimer.
Content
www.Efmny.org
Topics: Facts, Cause, Types & Symptoms, Diagnosis, Treatment, and First Aid.
Server| Server Location | |
| The New York Internet Company New York York United States 42.8713, -77.8856 | |
It is written for ASP.NET language. It has 2 DNS records, ns52.domaincontrol.com, and ns51.domaincontrol.com. The New York Internet Company (New York, York) is the location of the Microsoft-IIS/6 server.
IP: 64.90.180.134
Powered by: ASP.NET
Web Server: Microsoft-IIS/6
Encoding: utf-8
| Server Setup | |
| Content-Length: | 12982 |
|---|---|
| Content-Type: | text/html |
| Content-Location: | /index.html |
| Last-Modified: | -- |
| Accept-Ranges: | bytes |
| ETag: | "d2b29cad5eaccc1:f816" |
| Server: | Microsoft-IIS/6.0 |
| X-Powered-By: | ASP.NET |
| Date: | -- |